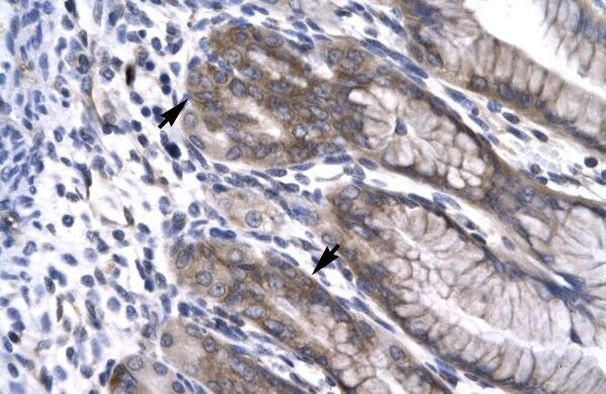
NPAS1 Antibody in Immunohistochemistry (Paraffin) (IHC (P))

Search
Invitrogen
NPAS1 Polyclonal Antibody
{{$productOrderCtrl.translations['antibody.pdp.commerceCard.promotion.promotions']}}
{{$productOrderCtrl.translations['antibody.pdp.commerceCard.promotion.viewpromo']}}
{{$productOrderCtrl.translations['antibody.pdp.commerceCard.promotion.promocode']}}: {{promo.promoCode}} {{promo.promoTitle}} {{promo.promoDescription}}. {{$productOrderCtrl.translations['antibody.pdp.commerceCard.promotion.learnmore']}}
产品信息
PA1-24403
宿主/亚型
分类
类型
抗原
偶联物
形式
浓度
保存条件
运输条件
RRID
产品详细信息
Predicted reactivity: Dog: 85%; Mouse: 92%; Pig: 92%; Rabbit: 100%; Rat: 92%.
Store product as a concentrated solution. Centrifuge briefly prior to opening the vial.
靶标信息
NPAS1 is a member of the basic helix-loop-helix (bHLH)-PAS family of transcription factors. Studies of a related mouse gene suggest that it functions in neurons. The exact function of this gene is unclear, but it may play protective or modulatory roles during late embryogenesis and postnatal development.
仅用于科研。不用于诊断过程。未经明确授权不得转售。